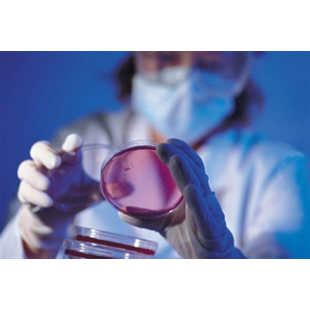
有機先端材料

全部-
-

新產品SEL X86 抗靜電系列
抗靜電伴隨科技的進步和電子產品的日益普及,靜電問題已成為許多行業的一大挑戰,特別針對電信、半導體、精密儀器和醫療設備領域....新產品SEL X86 抗靜電系列MORE -

車燈技術丨汽車燈具起霧原因及解決對策
噴塗防霧塗層是一種效果非常好的防霧方法,但在一些極端條件下,比如配光鏡內有過量濕度滯留,這些過量水珠會在短時間打破水與防霧塗層之間的平衡,超過其飽和 ...車燈技術丨汽車燈具起霧原因及解決對策MORE -

鏡面起霧困擾多,新材料塗層只要吸收光就達到防霧效果
冬天的汽車內側玻璃、熱氣蒸騰浴室內的鏡子、或戴著眼鏡從冷氣房走到炎熱室外、戴口罩時呼氣到眼鏡上,水蒸氣常遇冷而在鏡面上凝結成霧,解決方法不一.鏡面起霧困擾多,新材料塗層只要吸收光就達到防霧效果MORE -

AR減反射玻璃的應用
AR玻璃,即ANTI-REFLECTIVE GLASS,意為高增透性鍍膜玻璃,或減反射鍍膜玻璃。主要是基於奈米多孔二氧化矽技術,在玻璃表面鍍.....AR減反射玻璃的應用MORE